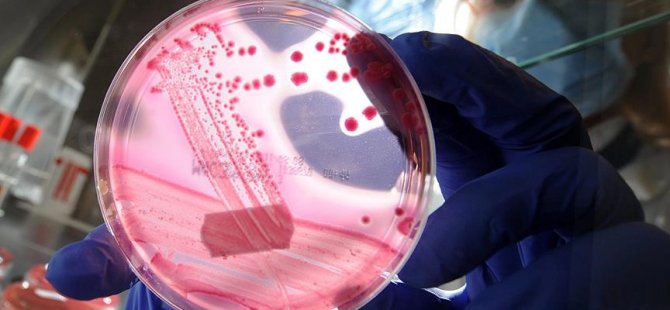

Sağlık Bakanlığınca video konferans yöntemiyle, "Spinal Müsküler Atrofi (SMA) Hastalığında Güncel Tedaviler Çalıştayı" düzenlendi. Çalıştaya, SMA Bilim Kurulu üyeleri, Bakanlık yetkilileri ve SMA dernekleri katıldı.
Bakanlıktan yapılan yazılı açıklamaya göre, toplantıda SMA Bilim Kurulu üyeleri, kullanılan SMA ilaçlarıyla ilgili verileri paylaştı ve son dönemde gündeme gelen muhtemel gen tedavisiyle ilgili en güncel bilimsel çalışmalar hakkında sunumlar gerçekleştirdi.
Sunumlarda, yakın zamana kadar herhangi bir tedavisi bulunmayan SMA için ilk kez 2016'da bir ilacın çıktığı, Türkiye'nin aynı sene bu ilacı tüm SMA tip-1 hastalarının erişimine ücretsiz sunan ilk ülkelerden olduğu ifade edildi. Bundan kısa süre sonra, birçok ülkenin aksine, hastalığın daha hafif formları olan tip-2 ve tip-3 hastaların da Türkiye'de ilaca ücretsiz erişiminin sağlandığı vurgulandı.
"Gen tedavisinin etkinliğine dair kanıtlar henüz yeterli düzeyde değil"
SMA hastalığının tedavisinin olmadığı ve hastaların 2 yaşına kadar gen tedavisi almazlarsa öleceği yönündeki iddiaların gerçeği yansıtmadığına işaret eden Bilim Kurulu, başvuru değerlendirmesi tamamlanan SMA hastalarının, etkinliği ve yan etkileri bilinen, Türkiye'de başarıyla uygulanan tedaviden halen faydalandığını belirtti.
Son zamanlarda geliştirilen ve gündemde olan gen tedavisine ilişkin verilerin, ilk süreçte olduğu gibi titizlikle incelemeye alındığını kaydeden Bilim Kurulu, sadece son 2 ayda yapılan 5 toplantıda ilaçla ilgili verilerin incelendiğini ifade etti.
Bilim Kurulu, şu bilgileri paylaştı:
"Gen tedavisinin etkinliğine dair bilimsel platformlarda yayımlanan kanıtlar henüz yeterli düzeyde değildir ve halihazırda uygulanan tedaviye üstünlüğüne dair kanıt bulunmamaktadır. Yapılan bazı çalışmalarda başta karaciğer yetmezliği ve trombosit sayısında düşüklük (kanama eğilimi) olmak üzere ciddi yan etkilerinin bulunduğu bildirilmiştir.
Ayrıca gen tedavisinin uygulama prosedürünün bir parçası olarak en az bir ay süreyle bağışıklık sisteminin baskılanması gerekmekte, özellikle kilosu daha yüksek bazı hastalarda bu süreç 1 yıla kadar uzayabilmektedir. Zaten kırılgan yapısı olan SMA tip-1 hastalarımızda enfeksiyonlar ve bağışıklık sisteminin baskılanması daha büyük risk oluşturmakta, herhangi bir hastalık seyri sırasında gidiş, hastalıktan bağımsız olarak ölümcül olabilmektedir."
Bilim Kurulu, tüm bu bilimsel veriler ışığında "mevcut verilerin fayda-zarar oranı konusunda yetersiz olması, hastalığın etkinliği bilinen bir tedavisinin zaten uygulanması ve Kovid-19 salgını sürecinde bağışıklığın baskılanmasının ölüm riskini artırabileceği gerekçeleriyle gen tedavisi uygulamasının şu an için uygun olmadığı, gelişmelerin takip edileceği" yönünde görüş belirtti.
SMA Bilim Kurulu, her ay yeni tedavi alternatifi konusundaki gelişmeleri takip etmek üzere toplanıyor, STK'lar ve aileler düzenli aralıklarla bilgilendiriliyor.

-001.gif)











































Türkçe karakter kullanılmayan ve büyük harflerle yazılmış yorumlar onaylanmamaktadır.